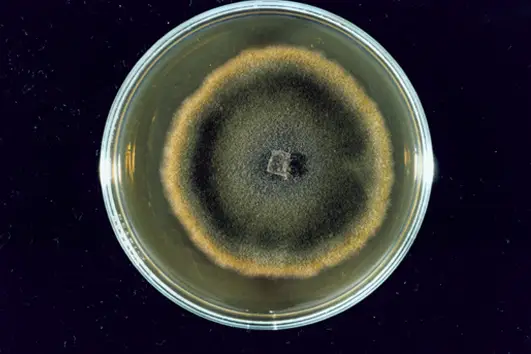

Přehled nejčastějších škůdců
Od nenápadného červotoče v trámu po rozsáhlé napadení dřevokaznou houbou ve sklepních prostorách. Škůdci nečekají — šíří se tiše, ale důsledně. My však víme, jak je zastavit. Rozpoznáme problém, navrhneme řešení a provedeme zásah, který má smysl. Bez zbytečných slibů, zato s jistotou výsledku.
6. 10. 2025
6. 10. 2025
6. 10. 2025
6. 10. 2025
6. 10. 2025
6. 10. 2025
6. 10. 2025
6. 10. 2025
6. 10. 2025
Houby a plísně
Pro dřevo zabudované ve vlhkém zdivu představují největší nebezpečí škůdci z řad dřevokazných hub. Odbourávají buď celulózu a dřevo postupně hnědne a kostkovitě se rozpadá, nebo lignin – pak materiál naopak zesvětlí, změkne a drobí se. Typickým znakem výskytu dřevokazné houby a plísně je mycelium, vatovité pletivo vytvořené z buněčných vláken, které prorůstá dřevěnou hmotou, nebo ulpívá na jejím povrchu.
Mezi nejčastější houby patří dřevomorka domácí, která dokáže zničit celé trámové konstrukce, ale i látky a plátna obrazů, koniofora sklepní (sklepní plíseň), trámovka, čechratka aj. Jedním z nejnápadnějších projevů některých druhů hub je modrání dřeva: houby nepůsobí hnilobu, ale vybarví část buněk dřevěné hmoty. Další skupinou hub napadajících dřevo jsou plísně projevující se barevnými skvrnami a zatuchlým zápachem patrným zvláště při vstupu do napadené místnosti z venkovního prostoru.
Dřevokazný hmyz
Živočišní škůdci poškozují dřevo především mechanicky. Vyhlodáváním spleti chodbiček, které ústí na povrch, se snižuje pevnost a nosnost konstrukcí, ničí se starožitnosti, nábytek. Typickým projevem výskytu dřevokazného hmyzu jsou hromádky jemných pilin vypadávajících z chodbiček. Pohybem hmyzu je však zajištěno také rozšíření hub a plísní, které škůdci zavlečou do nitra dřevní hmoty. Většina živočišných škůdců se do domu dostává už s řezivem: dospělý hmyz klade vajíčka do dřeva nebo na jeho povrch již v lese.
Z vajíčka se za určitý čas vyvine larva, která žije uvnitř dřeva a živí se jím. Z nejrozšířenějších hmyzích škůdců jsou to červotoč, dřevohlod, bělokaz, pilořitka, tesařík aj. Kromě tvaru a velikosti larvy je spolehlivým rozlišujícím znakem tvar vyhlodaných chodbiček.
Jak se účinně zbavit dřevokazných hub i hmyzu? Pomocí námi prováděné sanace. Přečtěte si o metodě likvidace dřevokazných škůdců, kterou používáme, více.